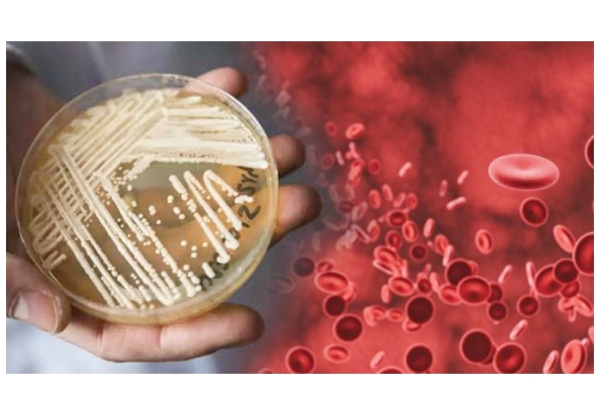
நேரடியாக ரத்த ஓட்டத்தை பாதித்து மரணத்தை கொடுக்கும் ‘கேண்டிடா ஆரிஸ்’ - புதிய பூஞ்சை கண்டுபிடிப்பு - அமெரிக்கா எச்சரிக்கை! | World

நேரடியாக ரத்த ஓட்டத்தை பாதித்து மரணத்தை கொடுக்கும் ‘கேண்டிடா ஆரிஸ்’ - புதிய பூஞ்சை கண்டுபிடிப்பு - அமெரிக்கா எச்சரிக்கை!
அமெரிக்காவில் மரணத்தை ஏற்படுத்தும் ‘கேண்டிடா ஆரிஸ்’என்ற புதிய தொற்று கண்டுபிடிக்கப்பட்டுள்ளதால் உலக நாடுகளிடையே பெரும் அச்சத்தை ஏற்படுத்தியுள்ளது.
கடந்த 2019ம் ஆண்டு டிசம்பர் மாதம் சீனாவில் பரவ ஆரம்பித்த கொரோனா வைரஸ் உலக நாடுகளில் உள்ள மக்கள் உயிரை பறித்துக் கொண்டு வருகிறது. இன்னமும் கொரோனா வைரஸ் பிடியில் மக்கள் சிக்கித் தவித்துக் கொண்டு வருகிறார்கள்.
மரணங்கள் நிகழுவதை எந்த நாடுகளாலும் தவிர்க்க முடியவில்லை. முதல் அலை, இரண்டாம் அலை, மூன்றாம் அலை என அடுத்தடுத்து கொரோனா வைரஸ் உருமாற்றம் அடைந்து பல லட்சக்கணக்கான மக்களை கொன்று குவித்து வருகிறது. தடுப்பூசி கண்டுபிடிக்கப்பட்டிருப்பினும் அதை செலுத்தி முடிப்பதற்குள் எத்தனை மரணங்கள் நிகழுமோ என்ற அச்சம் நீடித்துக் கொண்டு வருகிறது.
வைரஸ் உருமாற்றம் அடைந்தது போதாதென்று, கருப்பு பூஞ்சை, வெள்ளை பூஞ்சை, பச்சை பூஞ்சை, மஞ்சள் பூஞ்சை உள்ளிட்ட தொற்று பாதிப்புகளும் மக்களை ஆட்டிப்படைத்து வருகிறது.
இந்தியாவில் கண்டறியப்பட்ட கருப்பு பூஞ்சை நோய்க்கு இதுவரை நூற்றுக் கணக்கானோர் மரணமடைந்துள்ளனர். ஆரம்பத்திலேயே கண்டறியாவிட்டால் காப்பாற்றுவது கடினம். கொரோனா வைரஸால் பாதிக்கப்பட்டவர்களையே இந்த பூஞ்சை குறிவைத்து தாக்கி வருகிறது.இந்தியாவில், தற்போது கொரோனா பாதிப்பு குறைந்திருக்கும் நிலையில், கருப்பு பூஞ்சை தொற்றும் கட்டுக்குள் வந்துள்ளது.
இந்நிலையில், அமெரிக்காவின் டல்லாஸ் மற்றும் வாஷிங்டன் டி.சியில் உள்ள மருத்துவமனைகளில் உயிரிழப்பை ஏற்படுத்தக்கூடிய ‘கேண்டிடா ஆரிஸ்’ என்கிற புதிய பூஞ்சை தொற்று கண்டுபிடிக்கப்பட்டுள்ளது. இந்த பூஞ்சை தொற்று நேரடியாக ரத்த ஓட்டத்தை பாதித்து மரணத்தை விளைவிக்கக்கூடியதாம்.
இந்த பூஞ்சை தொற்றால் வாஷிங்டன் டி.சியில் 101 பேர் பாதிக்கப்பட்டுள்ளனர். டல்லாஸ் மாகாணத்தில் 22 பேருக்கு இந்த பூஞ்சை தொற்று உறுதியாகி இருக்கிறது. இந்த பூஞ்சை தொற்று குறித்த ஆய்வுகள் தற்போது தீவிரமாக நடைபெற்று வருகிறது.
நியூயார்க்கில் 3 பேர் உரிய சிகிச்சை பெற்று இந்த பூஞ்சை பாதிப்பில் மீண்டிருப்பதாக மருத்துவர்கள் தகவல் அளித்துள்ளனர்.